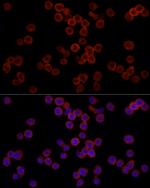
CD11b Antibody in Immunocytochemistry (ICC/IF)

Search
Invitrogen
CD11b Polyclonal Antibody
{{$productOrderCtrl.translations['antibody.pdp.commerceCard.promotion.promotions']}}
{{$productOrderCtrl.translations['antibody.pdp.commerceCard.promotion.viewpromo']}}
{{$productOrderCtrl.translations['antibody.pdp.commerceCard.promotion.promocode']}}: {{promo.promoCode}} {{promo.promoTitle}} {{promo.promoDescription}}. {{$productOrderCtrl.translations['antibody.pdp.commerceCard.promotion.learnmore']}}

Please note: We are reviewing Western blot images included in the antibody testing data in our catalog, including those provided by third parties. Unless expressly labeled or annotated as “raw-unedited”, Western blot images included in the antibody testing data in our catalog may have been edited, optimized or otherwise adjusted for presentation.
产品信息
PA5-90724
种属反应
已发表种属
宿主/亚型
分类
类型
抗原
偶联物
形式
浓度
规格
纯化类型
保存液
内含物
保存条件
运输条件
RRID
产品详细信息
Immunogen sequence: PQEDSDIAFL IDGSGSIIPH DFRRMKEFVS TVMEQLKKSK TLFSLMQYSE EFRIHFTFKE FQNNPNPRSL VKPITQLLGR THTATGIRKV VRELFNITNG ARKNAFKILV VITDGEKFGD PLGYEDVIPE ADREGVIRYV IGVGDAFRSE KSRQELNTIA SKPPRDHVFQ VNNFEALKTI QNQLREKIFA IEGTQT
Positive Samples: THP-1, Mouse spleen, Mouse lung; Cellular Location: Membrane, Single-pass type I membrane protein
靶标信息
CD11b (integrin alpha-M, ITGAM, integrin alpha-X, ITGAX) is a 165 kDa adhesion molecule that associates non-covalently with integrin beta-2 (CD18). The CD11b/CD18 heterodimeric complex is also known as integrin alpha-M beta-2, Mac-1, and CR3 (complement receptor 3). CD11b is expressed on the surface of monocytes/macrophages, granulocytes, activated lymphocytes, a subset of NK cells, a subset of dendritic cells, and microglia in the brain. CD11b/CD18 functions as the receptor for ICAM-1 (CD54), ICAM-2 (CD102), ICAM-4 (CD242), CD14, CD50, CD23, heparin, iC3b, fibrinogen, and Factor X -these adhesions are critical for cell-cell and cell-matrix interactions. CD11b is expressed on 8% of spleen cells, 44% of bone marrow cells, and less than 1% of thymocytes, and is commonly used as a microglial marker in nervous tissue. The expression of CD11b increases during monocyte maturation and expression levels vary on tissue macrophages. Further, peritoneal macrophages are reported to express higher levels of CD11b than splenic macrophages. Diseases associated with CD11b dysfunction include systemic lupus erythematosus 6 and ITGAM-related susceptibility to systemic lupus erythematosus.
仅用于科研。不用于诊断过程。未经明确授权不得转售。
生物信息学
蛋白别名: antigen CD11b (p170); CD11 antigen-like family member B; CD11b; CD11B (p170); cell surface glycoprotein MAC-1 alpha subunit; Cell surface glycoprotein MAC-1 subunit alpha; complement component 3 receptor 3 subunit; complement component receptor 3 alpha-a; complement receptor type 3; CR-3 alpha chain; glycoprotein Mac-1; human neutrophil antigen 4; Integrin alpha-M; integrin, alpha M (complement component 3 receptor 3 subunit); leukocyte adhesion glycoprotein precursor; Leukocyte adhesion receptor MO1; Mac-1 alpha; Mac-1 alpha (Mac1A); macrophage antigen alpha; macrophage antigen alpha polypeptide; macrophage-1 antigen alpha subunit; MGC117044; Neutrophil adherence receptor; neutrophil adherence receptor alpha-M subunit; unnamed protein product
基因别名: CD11B; CD11b/CD18; CR3; CR3A; F730045J24Rik; HNA-4; ITGAM; Ly-40; MAC-1; Mac-1a; MAC1; MAC1A; MO1A; SLEB6
Entrez Gene ID: (Human) 3684, (Mouse) 16409, (Rat) 25021




